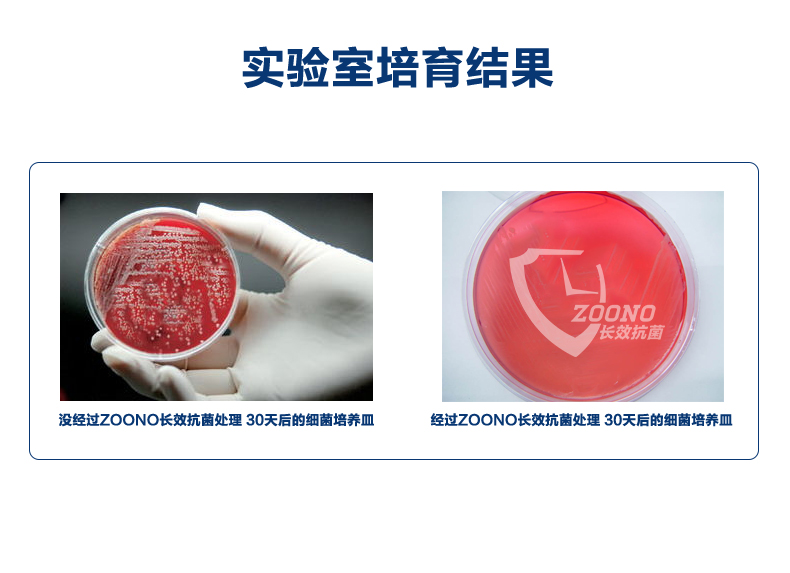

小贴士:
白菜哦精选超值好价,价格和库存都变动较快,想及时获取最新消息,推荐下载本站APP,每日白菜一手掌握!
30天长效抗菌,广谱杀灭,对H1N1、MERS等冠状病毒有效,经MERS病毒测试,杀菌率高达99.99%,防疫期间杀菌抑菌必备品。目前天猫商城zoono祖诺旗舰店售价¥198,可使用¥30优惠券,实付¥168包邮(15天内发货)。关注店铺收藏即赠免洗洗手液10ml。更多淘宝/天猫优惠券,可前往找虾米网查看。
新西兰进口 zoono 祖诺 长效消毒液150ml ,抗菌多合1,一瓶搞定多种细菌问题,权威报告证明:使用30天后抗菌能力仍达99%以上,气味如水般清新不刺激,可用在门把手、钥匙、方向盘、手机、马桶盖、玩具等物品上,防止病毒传播。
ZOONO是抗微生物制品牌,隶属于祖诺集团有限公司 ,总部设立在新西兰奥克兰市,官网在此。新西兰ZOONO集团拥有该长效消毒第9代技术的完整知识产权,可长效杀灭99.99%的细菌、病毒、霉菌、真菌、藻类等病原体,性状如清水,安全无毒,不伤人体,消毒效果已经得到美国、新西兰、澳大利亚、德国等多国检测机构验证。
来自度娘的技术解释:
提起ZOONO这个品牌,人们也许在国内很少听说过,但是它在国外是很有名气的。这个产品的技术脱胎于二战时期,当时德国人用来处理潜艇内部的空气污染以及舰艇外部的霉菌问题,二战结束后,作为战利品被美国拿走改良后继续用在海军中,2008年,美军放弃,因为最先进的科技都是用在军事上,美军有了更好的选择,所以放弃了这一技术,从而专为民用。新西兰祖诺公司购买了这一技术,并重新研发设计成适合民用的杀菌消毒产品,从而诞生了新一代先进的祖诺产品。祖诺产品均基于同样的技术原理研发。使用一种实际无毒的长链季铵盐作为活性物质,使用后在任何物体表面(无论硬表面或者软表面,无论皮肤还是物体)形成一层保护膜,保护膜上有无数针刺状的突起,这些针刺,与微生物的电荷相反,当微生物(病菌)接触到这些针刺的时候,细胞壁就会被刺破,达到杀菌消毒的目的。这个道理与用针刺气球是一样的,一根针能刺破多少个气球,没有人准确计算过,所以祖诺才能达到持久高效杀菌的目的。

H.B. Fuller 富乐 厨卫防霉防水玻璃胶 85mL装(无需工具)
史低4元包邮(需领券)
9.99元包邮(下单立减)
26.8元包邮(需领券)
15.9元包邮(需领券)
13.9元包邮(需领券)
19.8元包邮(需领券)
9.9元包邮(需领券)
9.9元包邮(需领券)
19.9元包邮(需领券)
小编推荐,Bayer 拜耳 拜灭士 Premise 杀蟑胶饵 5g
19.9元包邮(需领券)
15.16元包邮(双重优惠)
15.9元包邮(需领券)
日本品牌 旭包鲜 抽取式保鲜袋(小号100只/中号70只/大号50只)*10件
28元包邮(拍10件)
54.64元(新低13.66元/件)
5.8元包邮(需领券)
19.9元包邮(需领券)
管理评论

广州酒家 利口福 凤梨酥/核桃酥/黑金芝士薄脆饼干 160克*2盒

Beneunder 蕉下 昼望系列空曜 可折叠墨镜太阳镜 多色

桑村刘大姐 特级深海石花菜龙须菜 500g

费列罗首款高端黑巧系列,Ferrero Rocher 黑金三重奏 榛果威化黑巧克力 24粒装

香港美心旗下米其林一星饭店,翠园 臻选大粽子三珍馥郁礼盒 1.19kg

A1 爱逸 阿凡索芒果夹心面包 355g*2件

白菜!Lelizaza 冰伊莱 小苏打活性炭薄荷牙膏85g*4支装19.90元
26 0

白菜!Winner 稳健医疗 可水洗 UPF50+专业紫外线防护口罩*2件15.20元
17 0

白菜!新三板上市清真企业,春花邱食 即食酱牛腱子 300g*3袋49.00元
37 0

国家队运动员备战保障产品,优形 沙拉鸡胸肉100g*18袋*2件169.80元
55 0

白菜!NOME 诺米 2024夏季新款 220G重磅纯棉短袖男女T恤75.90元
95 0
-
最新评论
-
最热评论
0评论